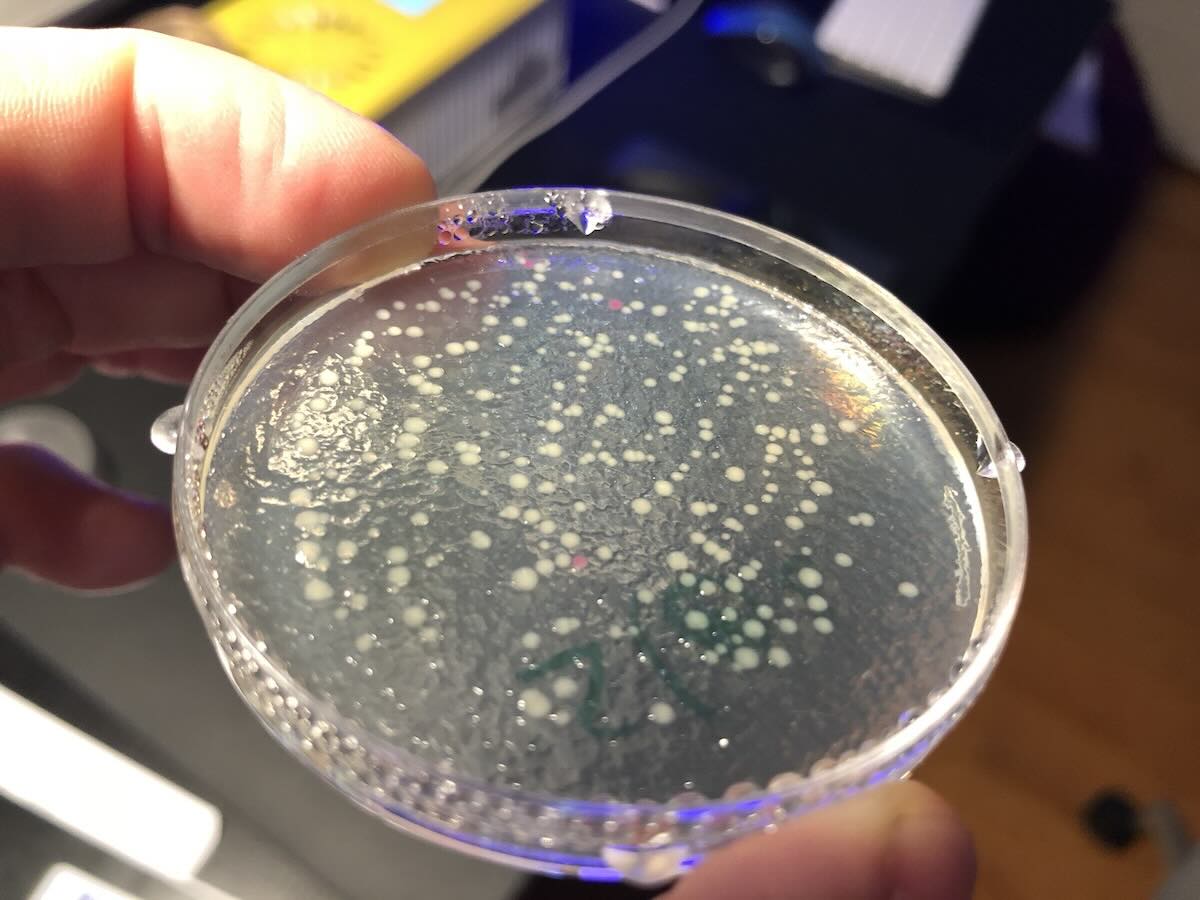
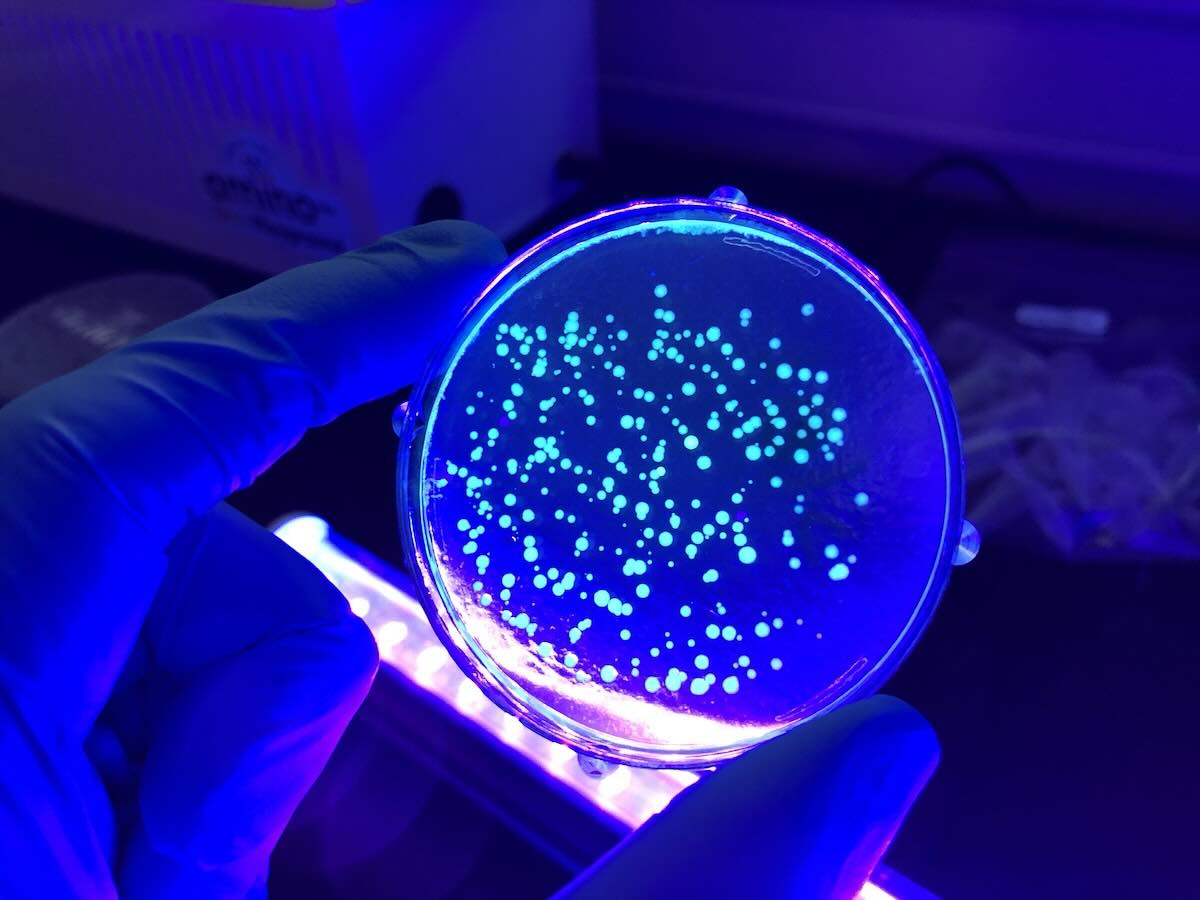

2018 Genetic Engineering
In 2018, I began to learn how to genetically engineer cells after my parents bought me a DNA Playground, a new kind of lab equipment designed by the Canadian start-up Amino Labs, for those just learning about biotechnology, molecular biology, and genetic engineering. It includes a “cold station”, a “hot station”, and a petri dish incubator, which eliminates the need to source ice buckets, a hot water bath, a thermometer, or ice. It is extremely handy!
Later that year, after doing various experiments like modifying cells to express different colors or smells, I was featured in a documentary about DIY biotechnology, produced by NHK (Japan Broadcasting Corporation).
Acknowledgements
Special thanks to Amino Labs founders Julie Legault and Justin Pahara, who introduced me to the magical world of genetic engineering, guided me along my first experiments and invited me to review and comment on their book Zero to Genetic Engineering Hero: The Beginner’s Guide to Programming Bacteria, which made me Junior Editor :-).